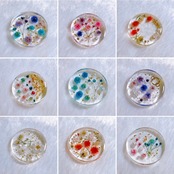

名入れ☆かすみ草のヘアゴム
¥1,600
International shipping available
本物のかすみ草を閉じ込めたヘアゴムです☆
お名前お入れいたします。
ご自身のお名前は勿論、
推しの名前やイニシャルだけでも⭐︎
かすみ草は
白色、ピンク色、赤色、水色、紫色
がございます❁⃘
写真は一例です。
全く同じ物は作れませんので、
お花の配列等はお任せになります。
ご希望がある場合はできる限り対応致しますので、備考欄にて教えてください⋆*❁*
世界にひとつだけのヘアゴムをお作りします❁
英文字(小文字、大文字)のみ対応しています。
備考欄に 入れる文字、文字の色、全体のイメージカラー等、詳しく記入していただけるとお好みの物をお作りできると思います♪
レジンを使って制作しております。
水や衝撃には弱くはないですが、長く使っていただく為にも、優しく扱ってくださいますと幸いです。
ラッピングも可能です。
ご希望の方はオプションを追加してください☆*°
※ ※ ※ ご購入時の注意点 ※ ※ ※
ご注文が入り次第、制作開始致します。
基本的には注文完了後のキャンセルはお受けできません。
なるべく早めの発送を心掛けておりますが、ひとつひとつ心を込めて作業している為、発送までお時間をいただくことがございます。
商品はお支払い完了後10日以内に発送致します。
2週間経っても発送されない場合は、一度お問い合わせください。
商品は全てハンドメイド作品の為、全く同じ物は作れません。
色や形、配置等が写真と異なることがございます。
注文を間違えた、イメージと違った等のお客様理由でのキャンセル.返品は致しかねますのでご了承ください。
不良品、故障等による交換等のお問い合わせは、到着後一週間以内にお願いいたします。
それ以降のご連絡には対応を致しかねますのでご了承ください。
細心の注意を心掛けておりますが、稀に小さな気泡や糸くず等が付いてしまう可能性がございます。
既製品のような完璧な商品は作れませんので、ハンドメイド作品にご理解いただける方のみご購入をお願い致します。
-
レビュー
(4)